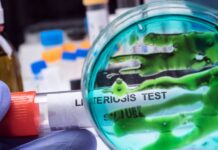
Seis muertes por brote de listeria vinculado a pastas preparadas

El seguro médico patrocinado por el empleador se ha convertido en una carga financiera cada vez más pesada para millones de familias en los Estados Unidos. Un nuevo informe revela que las primas anuales para la cobertura familiar promedio han alcanzado la alarmante cifra de $26,993 en 2025. Este costo, equivalente al de un automóvil Toyota Corolla híbrido nuevo, subraya la creciente crisis de los costos de salud en la nación.
Este dato proviene de una encuesta anual a empleadores publicada el 22 de octubre por KFF, una organización sin fines de lucro enfocada en información de salud.
El incremento imparable del seguro médico
El aumento en 2025 representa un alza del 6% en las primas de la cobertura médica familiar a través del trabajo. Es la primera vez en las últimas dos décadas que el costo de asegurar a una familia de cuatro personas ha subido un 6% o más durante tres años consecutivos, lo que indica una tendencia de costos preocupante.
Un peso que supera la inflación y los salarios
Durante los últimos cinco años, el precio promedio de la cobertura familiar se ha disparado un 26%. Este aumento es significativo, aunque ha quedado ligeramente por detrás del 29% de crecimiento en los salarios de los trabajadores. Sin embargo, supera al 24% del crecimiento de la inflación, lo que demuestra que los costos de salud están superando el índice general de precios. La prima anual media para un plan individual subió un 5% a $9,325, casi $3,000 más que en 2016.
Gary Claxton, autor del estudio y vicepresidente de KFF, expresó que «es preocupante porque los costos de salud siguen aumentando». Este sentimiento es compartido por pequeñas empresas, como Steve Reiff Inc. en South Whitley, Indiana, donde los costos aumentaron un 8% para el año fiscal 2026.
La carga del deducible
Además del encarecimiento de la prima, los trabajadores enfrentan deducibles cada vez más altos. Más de un tercio de los empleados con seguro están inscritos en un plan con un deducible de $2,000 o más por persona. La proporción de trabajadores en este tipo de plan ha aumentado un 32% en los últimos cinco años y un notable 77% en la última década, según el informe de KFF. En promedio, los empleados aportan $6,850 anualmente para la cobertura familiar.
Factores de aumento y la falta de acción política
Los expertos citan el alza en los costos de los medicamentos y la atención hospitalaria como los principales impulsores del aumento del seguro médico. Los pronósticos sugieren que las tendencias de costos serán aún más altas para 2026.
El dilema de los medicamentos para perder peso
Una preocupación creciente entre los empleadores es el elevado precio de los medicamentos GLP-1 para la pérdida de peso. Aunque muchas empresas están cubriendo estos tratamientos, el costo y la alta demanda están llevando a algunas a reconsiderar o restringir dicha cobertura. El alto precio de los medicamentos es un factor determinante en el aumento de las primas.
El debate político y el futuro del Medicaid y ACA
Mientras que el costo del seguro médico patrocinado por el empleador supera la inflación, el tema ha recibido poca atención en el Capitolio. La actual parálisis gubernamental se debe, en parte, a la disputa sobre la Ley de Atención Médica Asequible (ACA). Si el Congreso no actúa, los créditos fiscales que benefician a unos 22 millones de personas en los mercados de la ACA expirarán. Esto podría duplicar las primas para muchos consumidores a partir de enero, generando una grave inestabilidad en la cobertura médica.
Además, la ley de impuestos del presidente Donald Trump reduce miles de millones de dólares en gastos para Medicaid, el programa que proporciona cobertura médica a 70 millones de personas de bajos ingresos. Los analistas presupuestarios advierten que estos recortes podrían dejar a millones de personas sin seguro médico durante la próxima década. El estudio de KFF se basa en encuestas a 1,862 empleadores de todo el país. Para más información sobre tendencias de costos de salud, consulte el sitio web oficial de la organización KFF.
¿Cuál fue el aumento de la prima promedio de cobertura familiar en 2025?
La prima promedio para la cobertura familiar a través del trabajo se incrementó un 6% en 2025, alcanzando un total de $26,993 anuales.
¿Qué son los medicamentos GLP-1 y por qué preocupan a los empleadores?
Los medicamentos GLP-1 son tratamientos de alto precio para la pérdida de peso. Preocupan a los empleadores porque, a pesar de ser un beneficio importante, sus costos a menudo superan las expectativas y tienen un efecto significativo en el gasto farmacéutico del plan de salud.
¿Qué se espera que suceda con las primas de ACA sin la intervención del congreso?
Si el Congreso no aprueba la extensión de los créditos fiscales, las primas de los planes de la Ley de Atención Médica Asequible (ACA) podrían duplicarse para muchos consumidores a partir de enero.
Si ves algún error de cualquier tipo en esta información puedes escribirnos al email: info@latinoherald.com